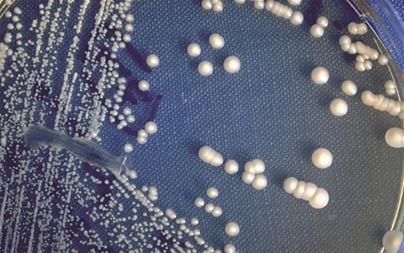
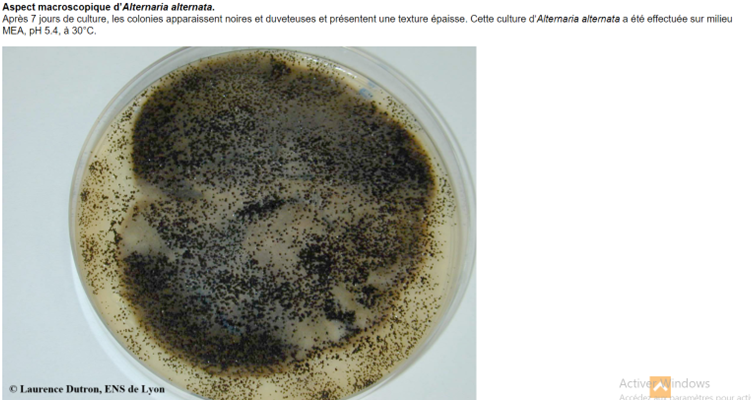

TD n01 : Caractérisation des champignons
1. Introduction sur les champignons
Les champignons constituent un règne à part dans le monde vivant. Ce sont des eucaryotes, c’est-à-dire que leurs cellules possèdent un noyau bien défini, des organites membranés et une paroi riche en chitine. Ils sont hétérotrophes : incapables de réaliser la photosynthèse, ils dépendent de la matière organique de leur environnement pour se nourrir.
Les champignons jouent un rôle essentiel dans :
· Les écosystèmes : décomposeurs de matière organique, recyclage des nutriments.
· L’industrie : production de pain, bière, vin, fromages, antibiotiques (pénicilline), enzymes industrielles.
· La médecine et l’agriculture : certains sont pathogènes (mycoses, maladies des plantes) ou symbiotiques (mycorhizes bénéfiques).
2. Classification générale
Les champignons se présentent sous différentes formes :
· Levures : organismes unicellulaires, se reproduisant principalement par bourgeonnement (ex. Saccharomyces cerevisiae).
· Moisissures : champignons filamenteux formant des réseaux de filaments appelés hyphes (ex. Aspergillus, Penicillium).
· Champignons filamenteux complexes : certains développent des fructifications macroscopiques, visibles à l’œil nu (ex. champignons de culture comestibles).
**Classification moderne des champignons (Fungi véritables)
Les groupes principaux actuellement reconnus appartiennent au Règne Fungi (Eumycota). Les plus importants sont :
|
Groupe (phylum) |
Caractéristiques clés |
Exemples |
|
Chytridiomycota (Chytridiomycètes) |
Champignons primitifs aquatiques, production de zoospores mobiles avec flagelle. Hyphes souvent coenocytiques. |
Batrachochytrium (pathogène des amphibiens) |
|
Zygomycota (au sens ancien) |
Ancien groupe aujourd’hui scindé (ex. Mucoromycota, Zoopagomycota) ; hyphes non septés, spores sexuées = zygospore. |
Rhizopus, Mucor |
|
Ascomycota |
Spores sexuées dans des asques (ascospores) ; plus grand phylum des champignons. |
Saccharomyces, Aspergillus, Penicillium |
|
Basidiomycota |
Spores sexuées = basidiospores portées par des basides. |
Champignons de Paris, rouilles, caries |
|
Glomeromycota |
Champignons formant des mycorhizes arbusculaires (symbiose racinaire). |
Glomus |
|
Microsporidia (souvent inclus dans Fungi) |
Parasites intracellulaires, spores très résistantes. |
Encephalitozoon |
3. Observation de différents types de champignons (à illustrer par ppt )
· Les levures : cellules arrondies ou ovales, isolées ou en bourgeonnement.
· Les moisissures : colonies duveteuses ou poudreuses présentant des hyphes et des structures reproductrices aériennes.
Discussion attendue : relever les différences de taille, d’organisation cellulaire et de reproduction entre levures et moisissures.

Aspect microscopique de levures à l’état frais (contraste de phase ; × 400).
Candida sp. Aspect macroscopique des colonies de levure en culture

4. Caractéristiques morphologiques
· Hyphes : filaments tubulaires qui constituent l’unité de base des moisissures. Ils peuvent être septés (présence de cloisons transversales) ou non septés (coenocytiques).
· Mycélium : réseau d’hyphes formant la structure végétative du champignon, responsable de l’absorption des nutriments. On distingue le mycélium végétatif (dans le substrat) et le mycélium aérien (portant les organes reproducteurs).
· Structures reproductrices : production de spores (sexuées ou asexuées) ou de conidies selon les groupes, permettant la dissémination et la survie dans l’environnement.
Tableau : Caractères morphologiques et systématiques des principaux groupes de champignons
